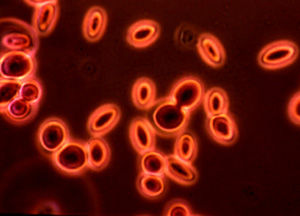
真核微生物

簡介
真核微生物微生物按照細胞核膜、細胞器及有絲分裂等的有或無,可劃分為原核微生物和真核微生物兩大類。
凡是細胞核具有核膜,能進行有絲分裂,細胞質中存線上粒體或同時存在葉綠體等細胞器的微小生物,都稱為真核微生物.
真核微生物有發育完好的細胞核,核內有核仁和染色質。有核膜將細胞核和細胞質分開,使兩者有明顯的界線。有高度分化的細胞器,如染色體、中心體、高爾基體、內質網、溶酶體和葉綠體等。進行有絲分裂。
特點
① 細胞核有核膜、核仁、能進行有絲分裂。
② 有線粒體、內質網等細胞器。
主要包括
真核微生物真菌 單細胞真菌:酵母菌
絲狀真菌:黴菌及大型真菌(蕈菌)
原生動物:特點:無細胞壁,屬無脊椎動物學。
單細胞藻類(除蘭藻):特點:有光合作用色素,能進行光合作用。是一類無機營養型的光合微生物。